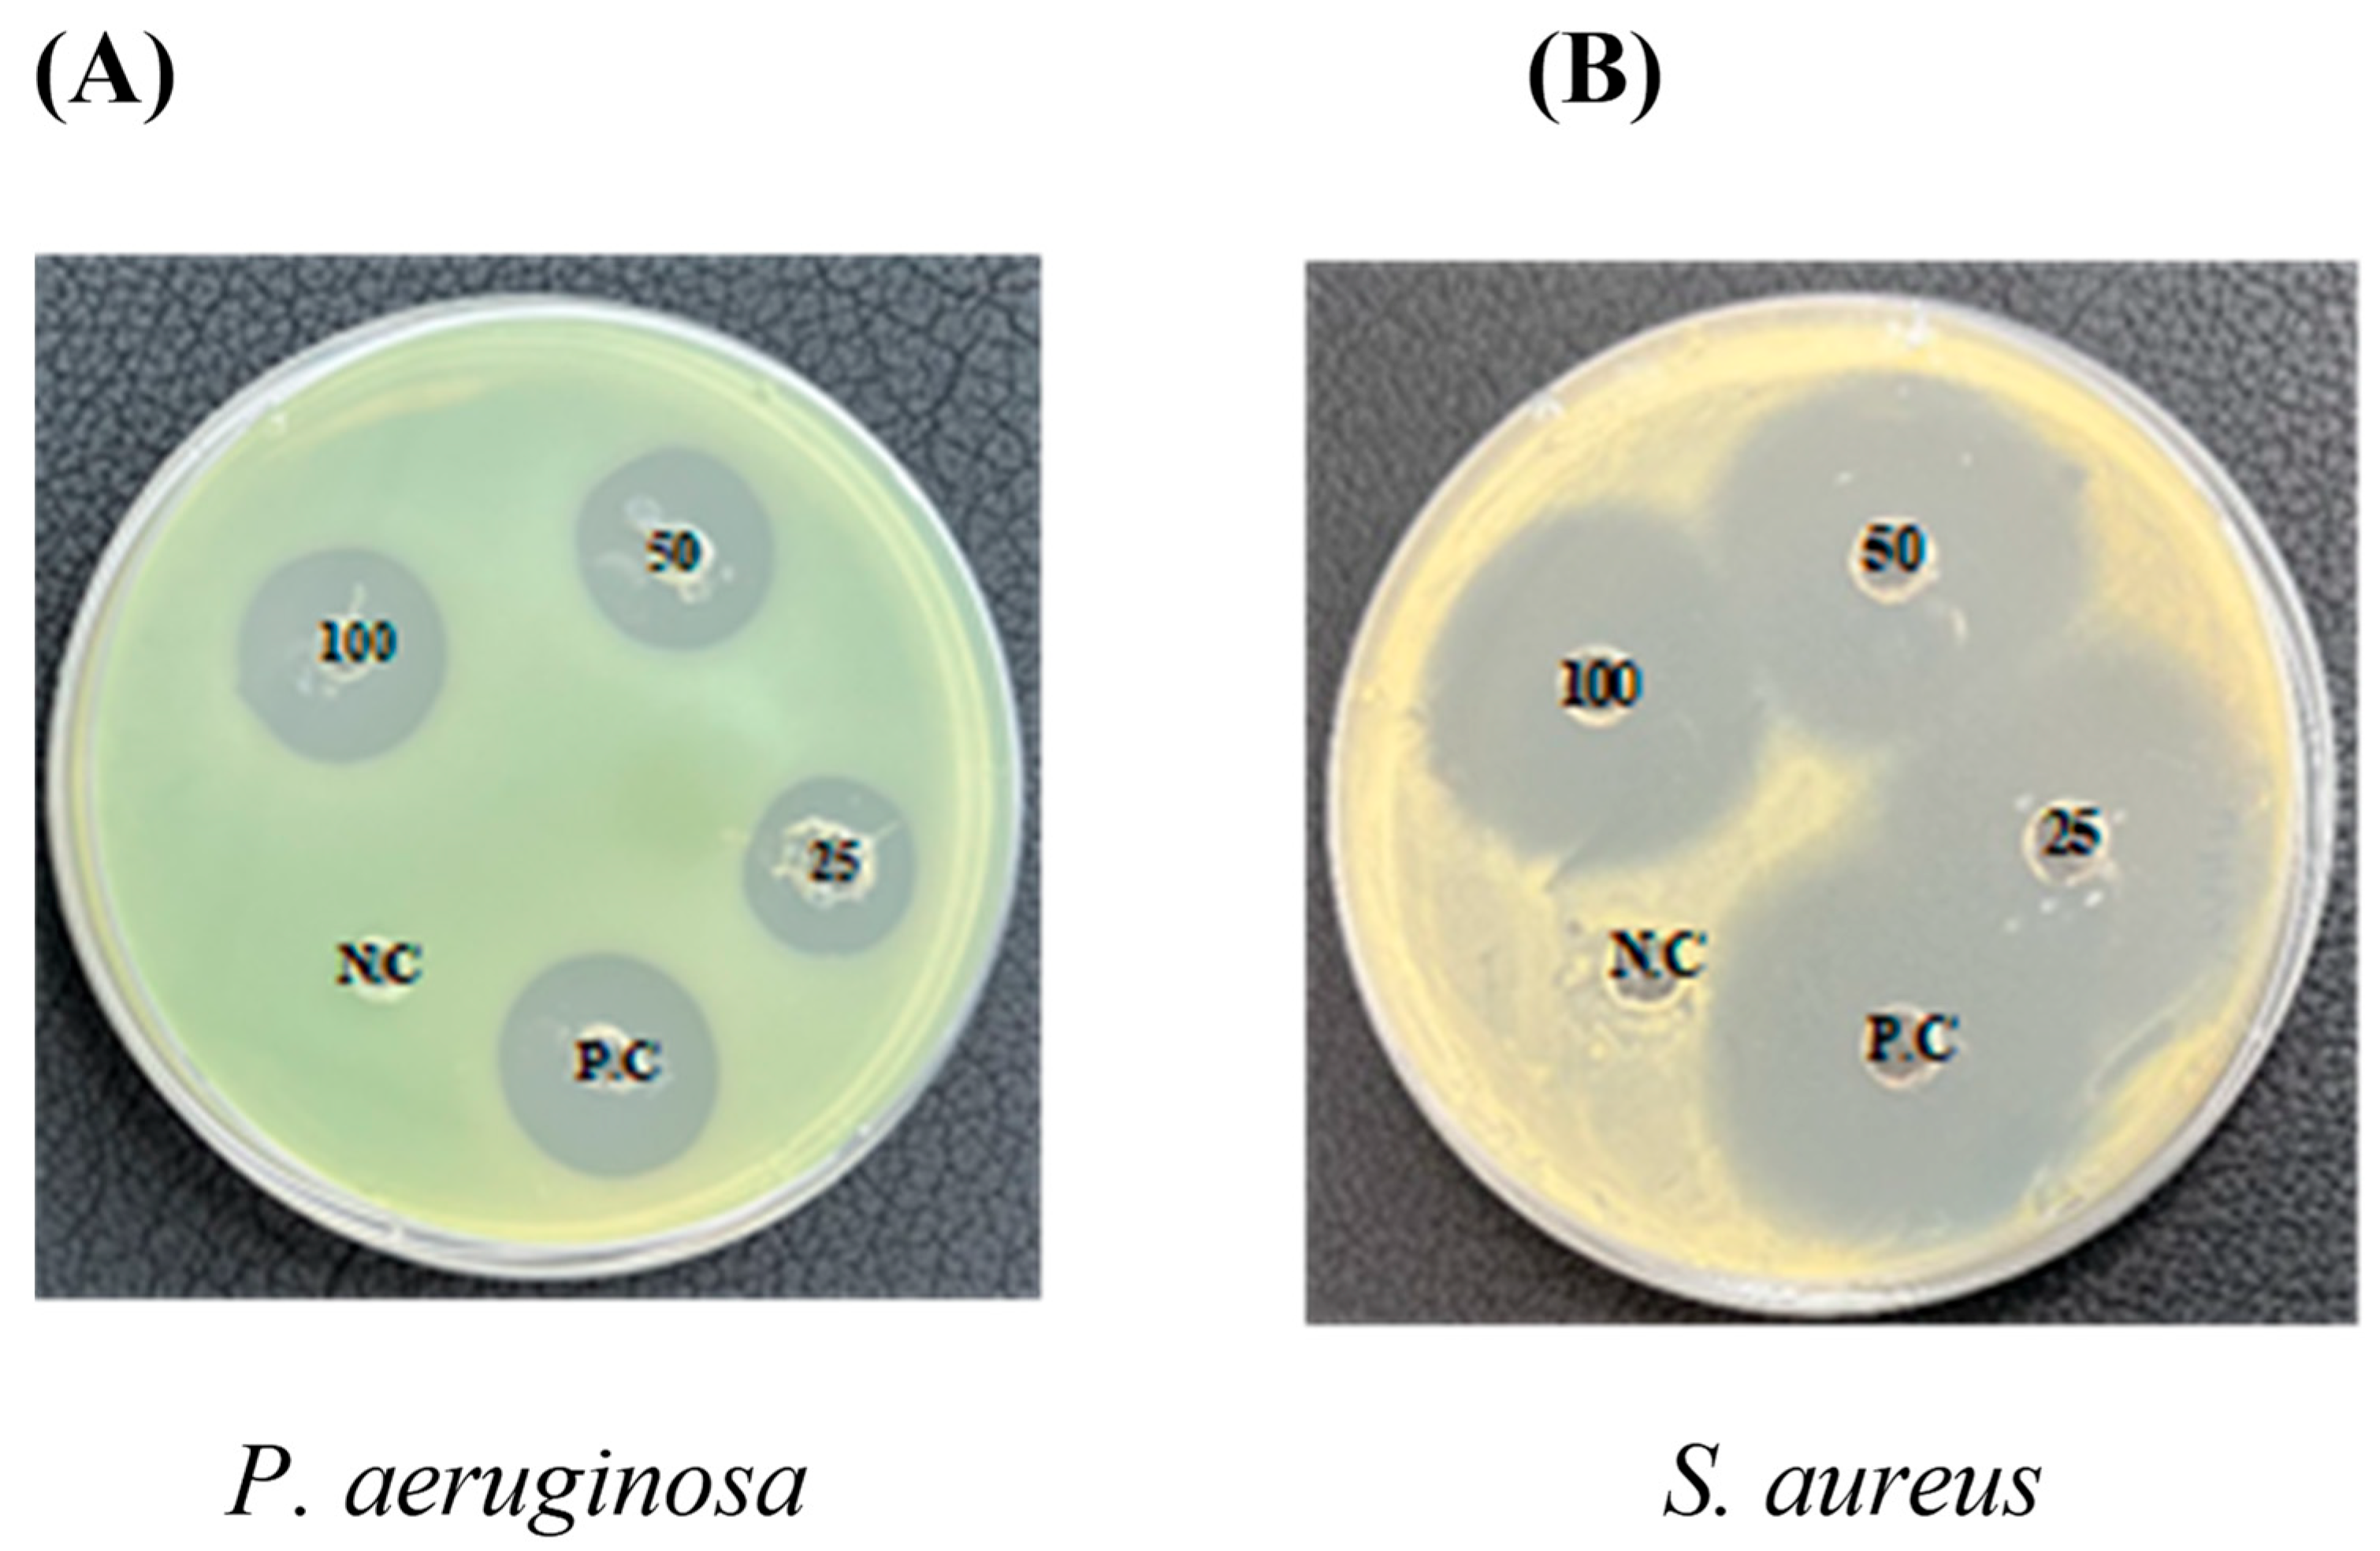

The Influence of κ-Carrageenan-R-Phycoerythrin Hydrogel on In Vitro Wound Healing and Biological Function
Abstract
1. Introduction
2. Results
2.1. Synthesis and Physical Characterization of κ-Carrageenan-R-Phycoerythrin Hydrogels
2.2. Rheological Properties of Hydrogels
2.3. Antioxidant Activity
2.4. Antibacterial Assays (Well Diffusion Method)
2.5. Cytotoxicity Studies
2.6. In Vitro Wound Healing
3. Discussion
4. Materials and Methods
4.1. Extraction and Purification of R-Phycoerythrin from Pyropia yezoensis
4.2. Purification
4.3. Synthesis and Characterization of κ-Carrageenan-R-Phycoerythrin Hydrogels
4.3.1. Swelling Analysis of Hydrogels
4.3.2. Biodegradation of Hydrogels
4.3.3. Rheological Properties of the Hydrogels
4.4. Antibacterial Activity
4.4.1. Bacterial Strains
4.4.2. Antibacterial Assays (Well Diffusion Method)
4.5. Antioxidant Activity
4.5.1. DPPH Assay
4.5.2. ABTS Assay
4.6. Cell Culture
4.6.1. MTS Assay
4.6.2. Live Dead Assay
Acridine Orange (AO) and PI Staining
4.6.3. In Vitro Wound Healing Scratch Assay
4.7. Statistical Analysis
5. Conclusions
Author Contributions
Funding
Institutional Review Board Statement
Informed Consent Statement
Data Availability Statement
Conflicts of Interest
References
- Kim, H.S.; Sun, X.; Lee, J.H.; Kim, H.W.; Fu, X.; Leong, K.W. Advanced Drug Delivery Systems and Artificial Skin Grafts for Skin Wound Healing. Adv. Drug Deliv. Rev. 2019, 146, 209–239. [Google Scholar] [CrossRef] [PubMed]
- Rodrigues, M.; Kosaric, N.; Bonham, C.A.; Gurtner, G.C. Wound Healing: A Cellular Perspective. Physiol. Rev. 2019, 99, 665–706. [Google Scholar] [CrossRef] [PubMed]
- Tottoli, E.M.; Dorati, R.; Genta, I.; Chiesa, E.; Pisani, S.; Conti, B. Skin Wound Healing Process and New Emerging Technologies for Skin Wound Care and Regeneration. Pharmaceutics 2020, 12, 735. [Google Scholar] [CrossRef] [PubMed]
- Wang, C.C.; Su, C.H.; Chen, C.C. Water Absorbing and Antibacterial Properties of N-Isopropyl Acrylamide Grafted and Collagen/Chitosan Immobilized Polypropylene Nonwoven Fabric and Its Application on Wound Healing Enhancement. J. Biomed. Mater. Res. Part A 2008, 84, 1006–1017. [Google Scholar] [CrossRef]
- Wang, C.C.; Su, C.H.; Chen, J.P.; Chen, C.C. An Enhancement on Healing Effect of Wound Dressing: Acrylic Acid Grafted and Gamma-Polyglutamic Acid/Chitosan Immobilized Polypropylene Non-Woven. Mater. Sci. Eng. C 2009, 29, 1715–1724. [Google Scholar] [CrossRef]
- Diegelmann, R.F.; Evans, M.C. Wound Healing: An Overview of Acute, Fibrotic and Delayed Healing. Front. Biosci. 2004, 9, 283–289. [Google Scholar] [CrossRef]
- Jones, V.; Grey, J.E.; Harding, K.G. ABC of Wound Healing: Wound Dressings. Br. Med. J. 2006, 332, 777–780. [Google Scholar] [CrossRef]
- Kim, I.Y.; Yoo, M.K.; Seo, J.H.; Park, S.S.; Na, H.S.; Lee, H.C.; Kim, S.K.; Cho, C.S. Evaluation of Semi-Interpenetrating Polymer Networks Composed of Chitosan and Poloxamer for Wound Dressing Application. Int. J. Pharm. 2007, 341, 35–43. [Google Scholar] [CrossRef]
- Wittaya-Areekul, S.; Prahsarn, C. Development and in Vitro Evaluation of Chitosan-Polysaccharides Composite Wound Dressings. Int. J. Pharm. 2006, 313, 123–128. [Google Scholar] [CrossRef]
- Hurlow, J.; Bowler, P.G. Acute and Chronic Wound Infections: Microbiological, Immunological, Clinical and Therapeutic Distinctions. J. Wound Care 2022, 31, 436–445. [Google Scholar] [CrossRef]
- Zhao, R.; Liang, H.; Clarke, E.; Jackson, C.; Xue, M. Inflammation in Chronic Wounds. Int. J. Mol. Sci. 2016, 17, 2085. [Google Scholar] [CrossRef]
- Lu, J.; Chen, Y.; Ding, M.; Fan, X.; Hu, J.; Chen, Y.; Li, J.; Li, Z.; Liu, W. A 4arm-PEG Macromolecule Crosslinked Chitosan Hy-drogels as Antibacterial Wound Dressing. Carbohydr. Polym. 2022, 277, 118871. [Google Scholar] [CrossRef]
- Anjum, S.; Arora, A.; Alam, M.S.; Gupta, B. Development of Antimicrobial and Scar Preventive Chitosan Hydrogel Wound Dressings. Int. J. Pharm. 2016, 508, 92–101. [Google Scholar] [CrossRef]
- Dong, Y.; Hassan, W.U.; Kennedy, R.; Greiser, U.; Pandit, A.; Garcia, Y.; Wang, W. Performance of an in Situ Formed Bioactive Hydrogel Dressing from a PEG-Based Hyperbranched Multifunctional Copolymer. Acta Biomater. 2014, 10, 2076–2085. [Google Scholar] [CrossRef]
- Zhao, X.; Wu, H.; Guo, B.; Dong, R.; Qiu, Y.; Ma, P.X. Antibacterial Anti-Oxidant Electroactive Injectable Hydrogel as Self-Healing Wound Dressing with Hemostasis and Adhesiveness for Cutaneous Wound Healing. Biomaterials 2017, 122, 34–47. [Google Scholar] [CrossRef]
- Moura, L.I.F.; Dias, A.M.A.; Leal, E.C.; Carvalho, L.; De Sousa, H.C.; Carvalho, E. Chitosan-Based Dressings Loaded with Neurotensin—An Efficient Strategy to Improve Early Diabetic Wound Healing. Acta Biomater. 2014, 10, 843–857. [Google Scholar] [CrossRef]
- Yang, C.; Xue, R.; Zhang, Q.; Yang, S.; Liu, P.; Chen, L.; Wang, K.; Zhang, X.; Wei, Y. Nanoclay Cross-Linked Semi-IPN Silk Sericin/Poly(NIPAm/LMSH) Nanocomposite Hydrogel: An Outstanding Antibacterial Wound Dressing. Mater. Sci. Eng. C 2017, 81, 303–313. [Google Scholar] [CrossRef]
- Yegappan, R.; Selvaprithiviraj, V.; Amirthalingam, S.; Jayakumar, R. Carrageenan Based Hydrogels for Drug Delivery, Tissue Engineering and Wound Healing. Carbohydr. Polym. 2018, 198, 385–400. [Google Scholar] [CrossRef]
- Graham, S.; Marina, P.F.; Blencowe, A. Thermoresponsive Polysaccharides and Their Thermoreversible Physical Hydrogel Networks. Carbohydr. Polym. 2019, 207, 143–159. [Google Scholar] [CrossRef]
- Dagnino-Leone, J.; Figueroa, C.P.; Castañeda, M.L.; Youlton, A.D.; Vallejos-Almirall, A.; Agurto-Muñoz, A.; Pavón Pérez, J.; Agurto-Muñoz, C. Phycobiliproteins: Structural Aspects, Functional Characteristics, and Biotechnological Perspectives. Comput. Struct. Biotechnol. J. 2022, 20, 1506–1527. [Google Scholar] [CrossRef]
- Lee, P.T.; Yeh, H.Y.; Lung, W.Q.C.; Huang, J.; Chen, Y.J.; Chen, B.; Nan, F.H.; Lee, M.C. R-Phycoerythrin from Colaconema Formosanum (Rhodophyta), an Anti-Allergic and Collagen Promoting Material for Cosmeceuticals. Appl. Sci. 2021, 11, 9425. [Google Scholar] [CrossRef]
- Ulagesan, S.; Nam, T.J.; Choi, Y.H. Extraction and Purification of R-Phycoerythrin Alpha Subunit from the Marine Red Algae Pyropia yezoensis and Its Biological Activities. Molecules 2021, 26, 6479. [Google Scholar] [CrossRef] [PubMed]
- Hemlata; Afreen, S.; Fatma, T. Extraction, Purification and Characterization of Phycoerythrin from Michrochaete and Its Biological Activities. Biocatal. Agric. Biotechnol. 2018, 13, 84–89. [Google Scholar] [CrossRef]
- Tecante, A.; Doublier, J.L. Steady Flow and Viscoelastic Behavior of Crosslinked Waxy Corn Starch-κ-Carrageenan Pastes and Gels. Carbohydr. Polym. 1999, 40, 221–231. [Google Scholar] [CrossRef]
- Rochas, C.; Rinaudo, M. Calorimetric Determination of the Conformational Transition of Kappa Carrageenan. Carbohydr. Res. 1982, 105, 227–236. [Google Scholar] [CrossRef]
- Chen, Y.; Liao, M.L.; Dunstan, D.E. The Rheology of K+-κ-Carrageenan as a Weak Gel. Carbohydr. Polym. 2002, 50, 109–116. [Google Scholar] [CrossRef]
- Takemasa, M.; Chiba, A.; Date, M. Gelation Mechanism of κ- and ι-Carrageenan Investigated by Correlation between the Strain-Optical Coefficient and the Dynamic Shear Modulus. Macromolecules 2001, 34, 7427–7434. [Google Scholar] [CrossRef]
- Yuguchi, Y.; Thu Thuy, T.T.; Urakawa, H.; Kajiwara, K. Structural Characteristics of Carrageenan Gels: Temperature and Concentration Dependence. Food Hydrocoll. 2002, 16, 515–522. [Google Scholar] [CrossRef]
- Yun, H.J.; Han, N.R.; An, H.W.; Jung, W.K.; Kim, H.W.; Lee, S.G. Development of an Abalone 3D Food Printing Ink for the Personalized Senior-Friendly Foods. Foods 2022, 11, 3262. [Google Scholar] [CrossRef]
- Abdillahi, H.S.; Verschaeve, L.; Finnie, J.F.; Van Staden, J. Mutagenicity, Antimutagenicity and Cytotoxicity Evaluation of South African Podocarpus Species. J. Ethnopharmacol. 2012, 139, 728–738. [Google Scholar] [CrossRef]
- Pettinelli, N.; Rodríguez-Llamazares, S.; Bouza, R.; Barral, L.; Feijoo-Bandín, S.; Lago, F. Carrageenan-Based Physically Crosslinked Injectable Hydrogel for Wound Healing and Tissue Repairing Applications. Int. J. Pharm. 2020, 589, 119828. [Google Scholar] [CrossRef]
- Annabi, N.; Nichol, J.W.; Zhong, X.; Ji, C.; Koshy, S.; Khademhosseini, A.; Dehghani, F. Controlling the Porosity and Microarchitecture of Hydrogels for Tissue Engineering. Tissue Eng. Part B Rev. 2010, 16, 371–383. [Google Scholar] [CrossRef]
- Şen, M.; Erboz, E.N. Determination of Critical Gelation Conditions of κ-Carrageenan by Viscosimetric and FT-IR Analyses. Food Res. Int. 2010, 43, 1361–1364. [Google Scholar] [CrossRef]
- Xu, Y.; Hou, Y.; Wang, Q.; Wang, Y. Study of Fluorescence Spectroscopy and Molecular Mechanisms for the Interaction of Hg2+ Ions and R-Phycoerythrin from Marine Algae (Porphyra yezoensis). J. Photochem. Photobiol. B Biol. 2022, 236, 112586. [Google Scholar] [CrossRef]
- Xu, Y.; Hou, Y.; Wang, Y.; Wang, Y.; Li, T.; Song, C.; Wei, N.; Wang, Q. Sensitive and Selective Detection of Cu2+ Ions Based on Fluorescent Ag Nanoparticles Synthesized by R-Phycoerythrin from Marine Algae Porphyra yezoensis. Ecotoxicol. Environ. Saf. 2019, 168, 356–362. [Google Scholar] [CrossRef]
- Chai, Q.; Jiao, Y.; Yu, X. Hydrogels for biomedical applications: Their characteristics and the mechanisms behind them. Gels 2017, 3, 6. [Google Scholar] [CrossRef]
- Dionísio, M.; Grenha, A. Locust Bean Gum: Exploring Its Potential for Biopharmaceutical Applications. J. Pharm. Bioallied Sci. 2012, 4, 175–185. [Google Scholar] [CrossRef]
- Kanai, H.; Navarrete, R.C.; Macosko, C.W.; Scriven, L.E. Fragile Networks and Rheology of Concentrated Suspensions. Rheol. Acta 1992, 31, 333–344. [Google Scholar] [CrossRef]
- Patel, S.N.; Sonani, R.R.; Jakharia, K.; Bhastana, B.; Patel, H.M.; Chaubey, M.G.; Singh, N.K.; Madamwar, D. Antioxidant Activity and Associated Structural Attributes of Halomicronema Phycoerythrin. Int. J. Biol. Macromol. 2018, 111, 359–369. [Google Scholar] [CrossRef]
- Sonani, R.R.; Singh, N.K.; Kumar, J.; Thakar, D.; Madamwar, D. Concurrent Purification and Antioxidant Activity of Phyco-biliproteins from Lyngbya Sp. A09DM: An Antioxidant and Anti-Aging Potential of Phycoerythrin in Caenorhabditis Elegans. Process Biochem. 2014, 49, 1757–1766. [Google Scholar] [CrossRef]
- Ha, H.T.; Cuong, D.X.; Thuy, L.H.; Thuan, P.T.; Tuyen, D.T.T.; Mo, V.T.; Dong, D.H. Carrageenan of Red Algae Eucheuma Gelatinae: Extraction, Antioxidant Activity, Rheology Characteristics, and Physicochemistry Characterization. Molecules 2022, 27, 1268. [Google Scholar] [CrossRef] [PubMed]
- Yuan, H.; Zhang, W.; Li, X.; Lü, X.; Li, N.; Gao, X.; Song, J. Preparation and in Vitro Antioxidant Activity of κ-Carrageenan Oligosaccharides and Their Oversulfated, Acetylated, and Phosphorylated Derivatives. Carbohydr. Res. 2005, 340, 685–692. [Google Scholar] [CrossRef] [PubMed]
- Trivedi, U.; Parameswaran, S.; Armstrong, A.; Burgueno-Vega, D.; Griswold, J.; Dissanaike, S.; Rumbaugh, K.P. Prevalence of Multiple Antibiotic Resistant Infections in Diabetic versus Nondiabetic Wounds. J. Pathog. 2014, 2014, 173053. [Google Scholar] [CrossRef] [PubMed]
- Bessa, L.J.; Fazii, P.; Di Giulio, M.; Cellini, L. Bacterial Isolates from Infected Wounds and Their Antibiotic Susceptibility Pattern: Some Remarks about Wound Infection. Int. Wound J. 2015, 12, 47–52. [Google Scholar] [CrossRef]
- Gjødsbøl, K.; Christensen, J.J.; Karlsmark, T.; Jørgensen, B.; Klein, B.M.; Krogfelt, K.A. Multiple Bacterial Species Reside in Chronic Wounds: A Longitudinal Study. Int. Wound J. 2006, 3, 225–231. [Google Scholar] [CrossRef]
- Fazli, M.; Bjarnsholt, T.; Kirketerp-Møller, K.; Jørgensen, B.; Andersen, A.S.; Krogfelt, K.A.; Givskov, M.; Tolker-Nielsen, T. Nonrandom Distribution of Pseudomonas Aeruginosa and Staphylococcus Aureus in Chronic Wounds. J. Clin. Microbiol. 2009, 47, 4084–4089. [Google Scholar] [CrossRef]
- Sudhakar, M.P.; Dharani, G.; Paramasivam, A. Evaluation of Antimicrobial, Antioxidant and Cytotoxicity Potential of R-Phycoerythrin Extracted from Gracilaria Corticata Seaweed. Curr. Res. Green Sustain. Chem. 2023, 6, 100352. [Google Scholar] [CrossRef]
- Zhu, M.; Ge, L.; Lyu, Y.; Zi, Y.; Li, X.; Li, D.; Mu, C. Preparation, Characterization and Antibacterial Activity of Oxidized κ-Carrageenan. Carbohydr. Polym. 2017, 174, 1051–1058. [Google Scholar] [CrossRef]
- Bera, S.; Zhanel, G.G.; Schweizer, F. Antibacterial Activities of Aminoglycoside Antibiotics-Derived Cationic Amphiphiles. Polyol-Modified Neomycin B-, Kanamycin A-, Amikacin-, and Neamine-Based Amphiphiles with Potent Broad Spectrum Antibacterial Activity. J. Med. Chem. 2010, 53, 3626–3631. [Google Scholar] [CrossRef]
- Kumar, J.P.; Bhardwaj, N.; Mandal, B.B. Cross-Linked Silk Sericin-Gelatin 2D and 3D Matrices for Prospective Tissue Engineering Applications. RSC Adv. 2016, 6, 105125–105136. [Google Scholar] [CrossRef]
- Atit, R.; Thulabandu, V.; Demeng, C. Dermal fibroblast in cutaneous development and healing. Wiley Interdiscip. Rev. Dev. Biol. 2018, 7, e307. [Google Scholar] [CrossRef]
- Aya, K.L.; Stern, R. Hyaluronan in Wound Healing: Rediscovering a Major Player. Wound Repair Regen. 2014, 22, 579–593. [Google Scholar] [CrossRef]
- Chen, W.Y.J.; Abatangelo, G. Functions of Hyaluronan in Wound Repair. Wound Repair Regen. 1999, 7, 79–89. [Google Scholar] [CrossRef]
- Dev, A.; Mohanbhai, S.J.; Kushwaha, A.C.; Sood, A.; Sardoiwala, M.N.; Choudhury, S.R.; Karmakar, S. κ-Carrageenan-C-Phycocyanin Based Smart Injectable Hydrogels for Accelerated Wound Recovery and Real-Time Monitoring. Acta Biomater. 2020, 109, 121–131. [Google Scholar] [CrossRef]
- Madhyastha, H.K.; Radha, K.S.; Nakajima, Y.; Omura, S.; Maruyama, M. UPA Dependent and Independent Mechanisms of Wound Healing by C-Phycocyanin. J. Cell. Mol. Med. 2008, 12, 2691–2703. [Google Scholar] [CrossRef]
- Lee, E.J.; Kang, E.; Kang, S.W.; Huh, K.M. Thermo-irreversible glycol chitosan/hyaluronic acid blend hydrogel for injectable tissue engineering. Carbohydr. Polym. 2020, 244, 116432. [Google Scholar] [CrossRef]
- Holder, I.A.; Boyce, S.T. Agar Well Diffusion Assay Testing of Bacterial Susceptibility to Various Antimicrobials in Concentrations Non-Toxic for Human Cells in Culture. Burns 1994, 20, 426–429. [Google Scholar] [CrossRef]
- Re, R.; Pellegrini, N.; Proteggente, A.; Pannala, A.; Yang, M.; Rice-Evans, C. Antioxidant Activity Applying an Improved ABTS Radical Cation Decolorization Assay. Free Radic. Biol. Med. 1999, 26, 1231–1237. [Google Scholar] [CrossRef]
- Shen, W.; Yan, M.; Wu, S.; Ge, X.; Liu, S.; Du, Y.; Zheng, Y.; Wu, L.; Zhang, Y.; Mao, Y. Chitosan Nanoparticles Embedded with Curcumin and Its Application in Pork Antioxidant Edible Coating. Int. J. Biol. Macromol. 2022, 204, 410–418. [Google Scholar] [CrossRef]
- Cory, A.H.; Owen, T.C.; Barltrop, J.A.; Cory, J.G. Use of an Aqueous Soluble Tetrazolium/Formazan Assay for Cell Growth Assays in Culture. Cancer Commun. 1991, 3, 207–212. [Google Scholar] [CrossRef]

| Micro-Organisms | Zone of Inhibition in mm | ||||
|---|---|---|---|---|---|
| Concentration of κ-CRG—R-PE | 25 µg/mL | 50 µg/mL | 100 µg/mL | P.C | N.C (κ-CRG) |
| P. aeruginosa | 8 ± 0.5 ** | 12 ± 0.72 ** | 15 ± 0.7 * | 22 ± 0.5 | - |
| S. aureus | 20 ± 1 ** | 22 ± 1.2 | 25 ± 0.75 * | 27 ± 1 | - |
Disclaimer/Publisher’s Note: The statements, opinions and data contained in all publications are solely those of the individual author(s) and contributor(s) and not of MDPI and/or the editor(s). MDPI and/or the editor(s) disclaim responsibility for any injury to people or property resulting from any ideas, methods, instructions or products referred to in the content. |
© 2023 by the authors. Licensee MDPI, Basel, Switzerland. This article is an open access article distributed under the terms and conditions of the Creative Commons Attribution (CC BY) license (https://creativecommons.org/licenses/by/4.0/).
Share and Cite
Ulagesan, S.; Krishnan, S.; Nam, T.-J.; Choi, Y.-H. The Influence of κ-Carrageenan-R-Phycoerythrin Hydrogel on In Vitro Wound Healing and Biological Function. Int. J. Mol. Sci. 2023, 24, 12358. https://doi.org/10.3390/ijms241512358
Ulagesan S, Krishnan S, Nam T-J, Choi Y-H. The Influence of κ-Carrageenan-R-Phycoerythrin Hydrogel on In Vitro Wound Healing and Biological Function. International Journal of Molecular Sciences. 2023; 24(15):12358. https://doi.org/10.3390/ijms241512358
Chicago/Turabian StyleUlagesan, Selvakumari, Sathish Krishnan, Taek-Jeong Nam, and Youn-Hee Choi. 2023. "The Influence of κ-Carrageenan-R-Phycoerythrin Hydrogel on In Vitro Wound Healing and Biological Function" International Journal of Molecular Sciences 24, no. 15: 12358. https://doi.org/10.3390/ijms241512358
APA StyleUlagesan, S., Krishnan, S., Nam, T.-J., & Choi, Y.-H. (2023). The Influence of κ-Carrageenan-R-Phycoerythrin Hydrogel on In Vitro Wound Healing and Biological Function. International Journal of Molecular Sciences, 24(15), 12358. https://doi.org/10.3390/ijms241512358

